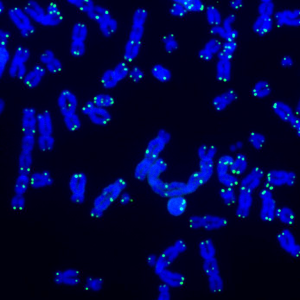

编辑推荐:
Salk的研究人员使用纳米孔原生长读测序技术开发了Telo-seq来解决端粒序列分析。Telo-seq还能可靠地区分端粒酶和ALT阳性癌细胞系。Telo-seq能够以前所未有的分辨率研究发育、衰老和癌症过程中的端粒生物学。
哺乳动物的端粒是真核线性染色体末端的保护性核蛋白结构。在我们每个细胞中,长链 DNA 折叠成染色体,被端粒的保护结构覆盖。随着年龄的增长,端粒会不断缩短,最终缩短到不能保护染色体末端(以至于我们的染色体末端暴露在外)引起细胞死亡。Salk研究所的研究人员开发了一种基于纳米孔测序的Telo-seq端粒测序技术,研究结果发表在新一期的《自然通讯》上。
显微镜图像显示(绿色)端粒,即(蓝色)染色体末端的保护帽,在细胞衰老中起着至关重要的作用。图片来源:Salk提供
端粒缩短是衰老的标志,也是防止无限增殖的一种巧妙的保护机制
具体来说,端粒包含5 ' -TTAGGG-3 '重复序列,并终止于一个富含G的单链突出尾(overhang)。突出部分可以折叠并形成端粒环(T环)。六聚体端粒蛋白复合物( shelterin)结合端粒重复序列并稳定T-环,共同保护端粒染色体末端不被识别为DNA双链断裂。由于“末端复制问题”和后续加工,人类体细胞的端粒会随着每一轮DNA复制而缩短。短的、去保护的端粒被DNA损伤反应识别,并触发永久性的细胞周期阻滞——复制性衰老,或者在缺乏p53和Rb检查点途径的细胞中,引发复制危机——这是一种广泛的先天免疫驱动的、依赖自噬的细胞死亡状态。复制性衰老和危机共同限制了人类体细胞的最大细胞分裂数量,这种端粒依赖性增殖屏障是对抗癌症生成的机制之一。
为了克服增殖障碍并获得不朽的复制,癌细胞必须激活端粒维持机制(TMM)。尽管大多数癌症重新激活逆转录酶端粒酶(TERT),但10-15%的癌症通过基于重组的“端粒选择性延长”(ALT)机制维持其端粒。正常人类体细胞中缺乏TMM,使得TMM特异性脆弱性成为个性化癌症治疗的诱人靶点,有效区分ALT+型还是TERT+型癌症非常重要。
基于长读测序的Telo-seq
现有测量端粒长度的方法包括末端限制片段(TRF)分析、STELA、TeSLA、定量PCR、Q-FISH、flow FISH、DNA组合和基于新一代测序数据的端粒长度估计。然而,由于端粒的重复性质和长度,这些传统方法无法解决染色体臂和单个端粒的等位基因特异性组成。
随着DNA长读测序的出现,完整分析人类端粒的长度和组成成为可能。来自Salk研究所的研究人员开发了Telo-seq,利用第三代测序的纳米孔测序有效地对整个人类端粒进行测序,并将其应用于研究衰老和癌症中人类端粒的体积、染色体臂和等位基因特异性长度和组成。
由于人类二倍体细胞的端粒含量大约仅占总基因组的0.015%,基于全基因组长读测序的端粒长度测量是低效的,端粒富集是必要的。作者用基于端粒的端粒adapters退火到G-overhang。用钝端限制性内切酶EcoRV消化基因组DNA。作者还采用已注释的亚端粒序列信息辅助将reads注释到单个染色体臂上。
研究成果
这项研究证明:Telo-seq是一种高效且可重复的方法,可以使用Oxford Nanopore Technologies的长读测序技术来确定整个人类端粒和部分邻近亚端粒的长度和序列。Telo-seq可以分析正常的复制危机细胞中的短端粒,也能分析ALT+癌细胞系中的超长端粒。
研究发现同一样本内端粒长度是异质性的。在单个样品中各染色体臂的端粒长度,甚至等位基因的端粒长度分布是不同的。尽管存在异质性,但一些染色体臂的端粒相对于平均端粒长度始终偏长或者偏短,这些染色体臂特异性端粒长度差异在不同个体之间是保守的。Telo-seq可以解析整体及染色体臂特异性端粒长度,并分辨仅5个PD(群体倍增)样本间的端粒缩短率;在某些情况下,还能解析等位基因特异性端粒长度。作者对来自20至94岁供体来源的成纤维细胞进行了Telo-seq,证实年轻人的端粒通常比老年人的更长,随着年龄的增长,端粒变短。
Telo-seq分析iPSCs中端粒长度重置
在诱导细胞多能性后,细胞的衰老特征被逆转,平均端粒长度被重置独立于亲本细胞的初始端粒长度。对25岁至94岁供体的成纤维细胞匹配的诱导多能干细胞(iPSCs)进行了端粒测序(Telo-seq)。iPSCs的端粒平均比其匹配的原代成纤维细胞长3202 bp。此外,与配对的成纤维细胞对照相比,iPSCs中长度超过10 kb的端粒比例增加了2至12倍。在iPSCs中,端粒长度分布的分散度降低,表明端粒酶活性导致端粒长度更均匀。与匹配成纤维细胞的端粒长度和供体年龄无关,iPSCs的平均端粒为8至10 kb,表明在这个范围内,人类iPSCs的端粒处于平衡状态,受端粒酶依赖的延伸和端粒修饰的调节。结论是在诱导多能性时,端粒酶优先延长较短的端粒,导致了整体端粒长度的增加,而且端粒长度分布更加均匀。但成纤维细胞和iPSCs之间的染色体臂特异性端粒长度的总体顺序保持一致。
Telo-seq可区分TERT+和ALT+癌细胞
癌细胞通过端粒酶或ALT19的再激活来维持其端粒。为了分辨这两种TMMs对端粒的影响,对5个TERT+和5个ALT+癌细胞系进行了Telo-seq。Telo-seq分析再现了TERT+和ALT+癌细胞系之间端粒长度分布的显著差异。在ALT+细胞中可以解析49 bp至134.7 kb的端粒长度,这表明Telo-seq是解决ALT+细胞中存在的超长端粒的有效方法。变异系数(CV)是对平均端粒长度分布的一种度量,绘制变异系数发现,ALT+癌细胞的CV都在0.8以上,而TERT+癌细胞的CV则小于0.55,这表明Telo-seq是区分癌细胞TMM的有效方法。这是在个性化癌症治疗中靶向TMM特异性漏洞的必要前提。
大多数人类染色体臂的亚端粒含有靠近端粒的CpG岛。Telo-seq使用天然DNA,可从长纳米孔读取中检索亚端粒DNA甲基化信息。亚端粒CpG岛在ALT+癌细胞系中经常呈低甲基化,但并不是所有的染色体臂都同样低甲基化。Telo-seq不仅可以测量端粒长度,还可以进行染色体臂特异性亚端粒甲基化分析。
对组织或分选细胞类型进行端粒测序不仅可以揭示精确的端粒长度测量,还可以提供有关人类衰老和疾病过程中端粒序列组成和亚端粒甲基化状态的信息。与全基因组测序相结合,Telo-seq将有助于研究遗传性端粒综合征,并解决潜在遗传改变对端粒结构的影响。研究突出了人类端粒长读测序的潜力,并为在发育、衰老和疾病过程中以前所未有的细节研究人类端粒动力学奠定了基础。
作者视角
该研究的资深作者Jan Karlseder表示:“以前测量端粒长度的方法分辨率低,而且相当不准确。” “我们可以假设单个端粒可能在衰老和癌症中发挥作用,但根本无法验证这些假设。“
Karlseder 及其同事与牛津纳米孔技术公司的专家密切合作,将他们的长读测序技术与新颖的生物化学和生物信息学方法相结合。由此产生的方法从每个端粒的末端开始,并很好地测序到亚端粒区域。这使科学家能够识别他们正在研究的染色体,并详细检查其端粒结构和组成。
利用这项技术,研究人员描述了许多以前科学家无法获得的端粒生物学特征。到目前为止,他们观察到在单个人类样本中,每个染色体臂可以具有不同的端粒长度,并且这些端粒的缩短率可以有很大差异。这些动态在同一人的不同组织和细胞类型中也有所不同,原因可能有很多,包括影响身体不同部位的压力和炎症程度。总之,这表明存在潜在的染色体臂特异性因素影响衰老和疾病中的端粒动态。
“衰老是一个非常复杂的过程,对每个人的影响都不同,”“我们非常感兴趣的是,衰老的差异是否与人或染色体之间不同的端粒缩短率有关,以及我们如何能够减缓这一速度以促进健康衰老。”
Telo-seq 还可以提高我们对端粒驱动疾病的理解。许多端粒病都涉及干细胞,这些干细胞端粒长度耗尽,无法分裂成新的功能性细胞。这可能导致脱发、免疫紊乱或某些癌症。Telo-seq 将使科学家能够研究这些疾病是在家族内遗传还是与个体染色体有关,以便制定更有针对性的干预措施。
虽然端粒缩短会对细胞寿命产生毁灭性的影响,但相反的情况也同样具有破坏性。当端粒修复机制过度激活时,细胞会进入“永生”状态并无限分裂,从而导致癌症。为了修复受损的端粒,细胞可以使用端粒酶或另一种称为端粒替代延长 (ALT) 的机制。端粒的长度和组成会因所用的维护机制而异,但到目前为止,科学家或临床医生还没有有效的方法来测量这一点。
“使用 Telo-seq,我们可以快速确定癌症是端粒酶阳性还是 ALT 阳性,”第一作者、Karlseder 实验室的博士后研究员 Tobias Schmidt 表示,“这至关重要,因为 ALT 阳性癌症通常更具侵袭性,需要与端粒酶阳性癌症不同的治疗方法。从这个意义上讲,Telo-seq 可以用作快速可靠的诊断工具,以识别癌症类型并指导更个性化的治疗计划。”
除了许多直接的临床应用之外,Karlseder 和 Schmidt 表示,Telo-seq 的最大影响将是开启端粒研究的新时代。“Telo-seq 将使我们能够解答有关发育、衰老、干细胞和癌症的问题,而这些问题我们无法用以前的工具来解决,”Karsleder 说。“我们甚至不知道我们错过了什么,我认为我们现在开始了解的东西实际上只是冰山一角。这是端粒科学的一个激动人心的时刻。”

从左至右:Jeffrey Jones、Rusty Gage、Tobias Schmidt 和 Jan Karlseder。图片来源:Salk提供
生物通 版权所有